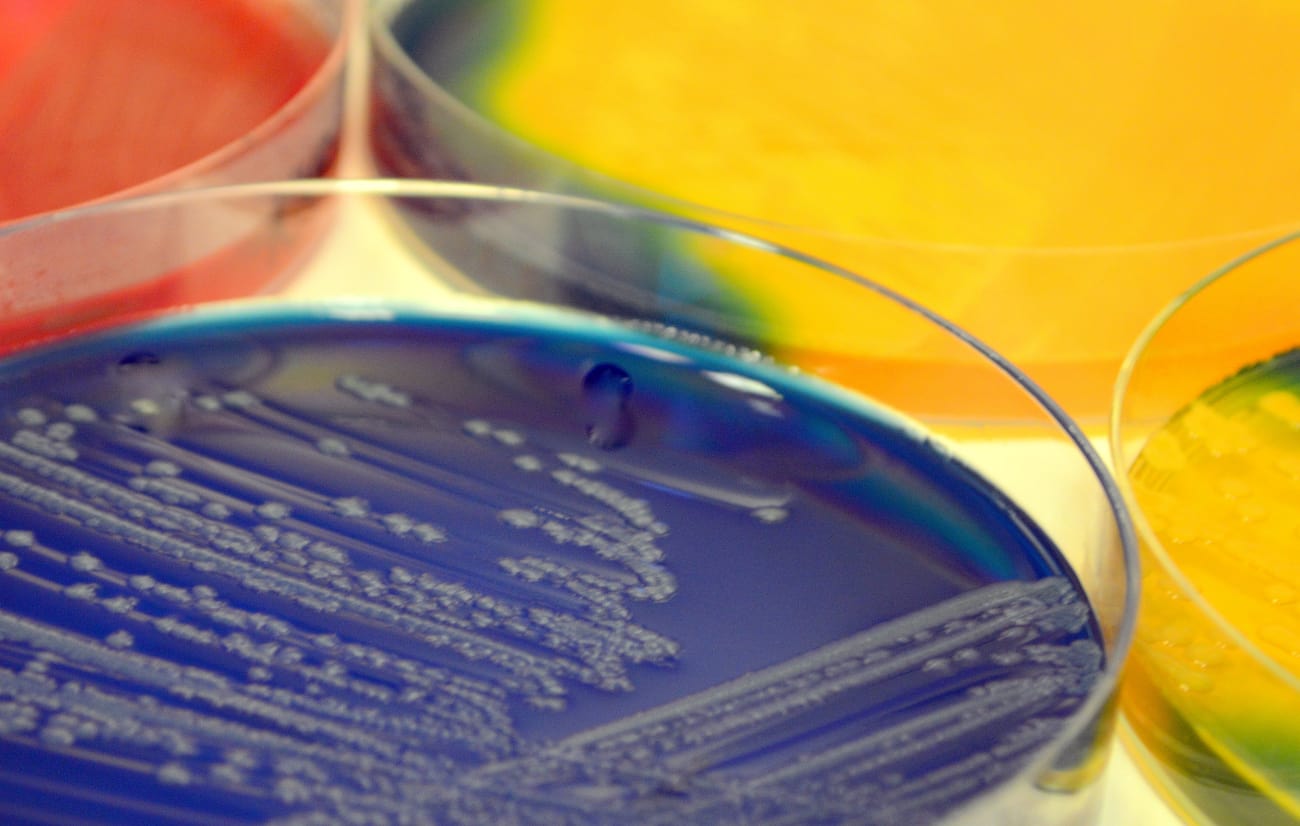

New Directions in Preventing Neonatal Dysbiosis
Necrotizing enterocolitis—or NEC, for short—is one of the leading causes of death in infants. Doctors know that premature babies are more vulnerable to NEC than full-term infants, but the reasons are not altogether clear. Preventing and treating the condition is particularly challenging.
NEC and other serious conditions in infancy, such as sepsis and even developmental delays, are related to an unhealthy imbalance of bacteria in the infants’ digestive tracts, a condition known as dysbiosis.
“It starts in the gut when bad bacteria take control,” says Akhil Maheshwari, director of neonatology at Johns Hopkins Children’s Center.
Prevailing wisdom has been that premature infants are more prone to dysbiosis because they spend a great deal of time in the hospital after birth, where they contract the harmful bacteria from other infants—a trajectory neonatologists and microbiologists refer to as horizontal acquisition.
A new study by Maheshwari has flipped that understanding on its head. The study’s counterintuitive results have opened up new understandings about how infants become colonized by unhealthy bacteria—and they offer intriguing new directions in the battle against dysbiosis. The study was published in the Sept. 12 issue of Microbiome.
Dysbiosis is a concern because the microbial imbalance is tipped in favor of a class of microbes known as gammaproteobacteria, which includes the pathogens that cause typhoid, gonorrhea, plague, cholera and other well-known infectious diseases, as well as E. coli, which can cause deadly food poisoning in children.
Maheshwari set out to determine how these unwanted bacteria come to thrive in premature infants, who have a higher rate of developing full-blown dysbiosis. His study shows that preterm babies who develop dysbiosis fall into two categories: Half begin life with low levels of gammaproteobacteria in their intestines and are colonized in the first few weeks after birth; the other half of babies have extremely high levels of these bacteria as soon as they are born. Maheshwari’s study is the first to demonstrate this dual-track dichotomy in the progression of dysbiosis.
More critically, however, is what the study says about how the infants acquired the bacteria. Both groups are born with gammaproteobacteria and did not initially acquire them from other infants, as prevailing hypotheses would have it. There must be another source.
“It suggests the bad bacteria come directly from the mother to the child, not from other infants—what is known as a vertical trajectory,” Maheshwari says.
At the same time, doctors also know that mothers who carry full term do not have the gammaproteobacteria in their blood, milk, feces or other bodily fluids. “If full-term moms don’t have them and preterm moms do, where did they come from?” Maheshwari asks rhetorically.
The answer is in the data. He now believes that the bad bacteria are acquired not by infants from other infants, but by the mothers during lengthy and sometimes numerous hospital stays intended to stave off preterm delivery. Sixty percent of mothers in preterm labor are admitted to the hospital three or four times, he says, and many more have at least two admissions.
Transmission from mother to child would also explain another fact about dysbiosis: Vaginal birth, in which infants are more likely to come in contact with blood, feces and other bodily fluids from the mother, leads to greater likelihood of developing the condition among preterm babies whose mothers were hospitalized prior to their birth.
“Colonization in mothers happens long before birth, and the mothers are passing it on,” Maheshwari says. “We can use this knowledge to prevent dysbiosis.”
Based on the findings from his own study, Maheshwari has begun a broad collaboration with his obstetrics colleagues to implement new admission policies and procedures at Johns Hopkins Children’s Center to counteract dysbiosis.
Rather than attacking microbial imbalances after the fact—in already colonized newborns, by disinfecting NICUs or administering antibiotics—the fight needs to begin much sooner, ideally from the moment the mother goes into preterm labor, he says. Maheshwari believes that potential risks of hospital stays for preterm labor should be more carefully considered, and such stays should be avoided or limited to the greatest extent possible.
“Doctors need to start prevention before delivery,” he says. “If we wait until birth, it’s already too late.”